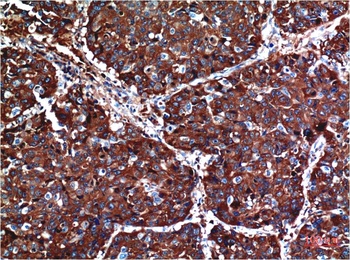
AKT (1H2) Mouse mAb Antibody

You have no items in your shopping cart.
AKT Mouse Monoclonal Antibody
Description
Research Area
Images & Validation
−| Tested Applications | ICC, WB |
|---|---|
| Dilution Range | WB=1:1000-5000, ICC/IF=1:100-500 |
| Reactivity | Human |
Related Conjugates & Formulations
−Key Properties
−| Antibody Type | Primary Antibody |
|---|---|
| Host | Mouse |
| Clonality | Monoclonal |
| Isotype | IgG |
| Clone No. | 10D8 |
| Immunogen | KLH conjugated synthetic peptide derived from human AKT (420-479/479aa) |
| Target | AKT1 |
| Molecular Weight | 56 kDa |
| Purification | Affinity purified by Protein G |
| Conjugation | Unconjugated |
Storage & Handling
−| Storage | Maintain refrigerated at 2-8°C for up to 2 weeks. For long term storage store at -20°C in small aliquots to prevent freeze-thaw cycles. |
|---|---|
| Form/Appearance | Liquid |
| Buffer/Preservatives | 0.01M TBS (pH7.4) with 1% rAlbumin, 0.02% Proclin300 and 50% Glycerol. |
| Concentration | 1mg/ml |
| Expiration Date | 12 months from date of receipt. |
| Disclaimer | For research use only |
Alternative Names
−Similar Products
−Phospho-AKT (Ser473) Mouse Monoclonal Antibody [orb506119]
IF, IHC-Fr, IHC-P
Bovine, Canine, Porcine, Rabbit, Sheep
Human, Mouse, Rat
Mouse
Monoclonal
Unconjugated
200 μg, 50 μl, 100 μl, 200 μl

Quality Guarantee
Explore bioreagents carefree to elevate your research. All our products are rigorously tested for performance. If a product does not perform as described on its datasheet, our scientific support team will provide expert troubleshooting, a prompt replacement, or a refund. For full details, please see our Terms & Conditions and Buying Guide. Contact us at support@biorbyt.com.

Sample: MCF-7 (Human) Cell Lysate at 30 ug, A549 (Human) Cell Lysate at 30 ug, Hela (Human) Cell Lysate at 30 ug, Primary: Anti-AKT (orb526606) at 1/1000 dilution, Secondary: IRDye800CW Goat Anti-Mouse IgG at 1/20000 dilution, Predicted band size: 56 kD, Observed band size: 56 kD.

Tissue/Cell: Hela cell, 4% Paraformaldehyde-fixed, Triton X-100 at room temperature for 20 min, Blocking buffer (normal goat serum) at 37°C for 20 min, Antibody incubation with (MAKT) Monoclonal Antibody, Unconjugated (orb526606) 1:100, 90 minutes at 37°C, followed by a conjugated Goat Anti-Mouse IgG-CY3 antibody at 37°C for 90 minutes, DAPI (blue) was used to stain the cell nuclei.
Quick Database Links
UniProt Details
−Documents Download
Request a Document
Protocol Information
AKT Mouse Monoclonal Antibody (orb526606)
Participating in our Biorbyt product reviews program enables you to support fellow scientists by sharing your firsthand experience with our products.
Login to Submit a Review